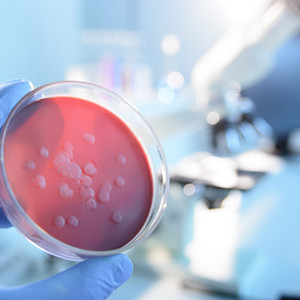
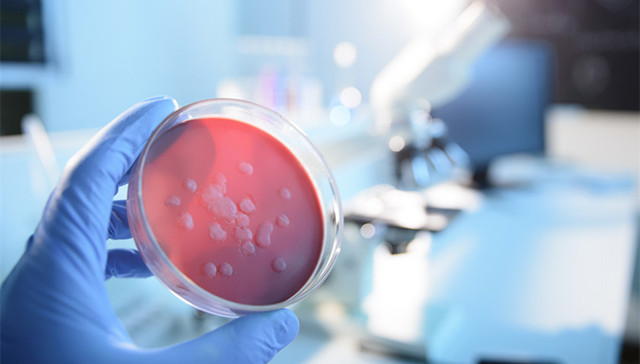
湖北卫健委：新冠肺炎进入第二波流行上升期

据央视新闻客户端消息,2020年1月24日,湖北省召开新型冠状病毒感染的肺炎疫情防控工作例行新闻发布会。会上,湖北省卫健委通报了全省疫情和防控工作最新进展情况。
湖北省卫健委副主任柳东如表示,当前,之所以有大量的发热病人在门诊就诊,专家认为,这是因为当前正值疾病高发期,流感流行的高峰期,同时,新型冠状病毒感染的肺炎进入第二波流行的上升期,三期叠加,所以现在的发热病人急剧增加,再加上少数患者受一些不实信息的影响,恐慌性就医,大致目前发热病人增加。目前全省有549家以上医疗机构和所有乡镇卫生院都设置了发热门诊,其他医疗机构设置了预检分诊点和发热病人诊室,其中武汉市有61家医疗机构有发热门诊,所有的社区卫生服务中心都有发热诊室,可以开展发热病人的筛查和鉴别诊断,各医疗机构在接诊发热病人后,便能明确判断就地治疗,在不能明确发热原因的情况下,方需转诊到转诊的医院做鉴别诊断。